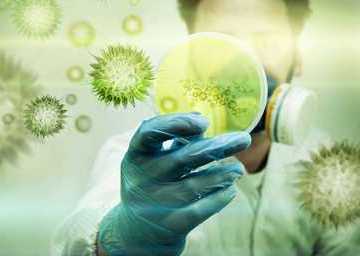

Дератация, дезинфекция, дезинсекция
Специалисты дезинфекционного отделения "GIO TRADE" проводят комплексные мероприятия по дерматизаци, дещинсекции на объектах любой формы собственности. осуществляется переработка зерна и лифтов. Собственная лаборатория по производству токсичнных соединений.
Работа по дерегулированию включает в себя осмотр помещенийЮ объектов и прилегающей территории, спецификацию превентивного работника для учучшения защиты объекта и последующий контроль над текущим контрактом.
Дезинфекция - комплексные меры по устранению инфекционных и паразитарных заболеваний при инфекционных заболеваниях.
Дезинсекция - пути и средства борьбы с церебральным параличом (насекомые и клещи), распространение инфекционных заболеваний, наносящие ущерб сельскохозяйственным продуктам и домам людей.
Дератизация - комплексные меры по ликвадации грызунов (мышей и крыс) и держать их как минимум на регулярной основе.
Квалифицированные специалисты со специльным образованием, которые каждые три года проводят переквалификацию, используя производные препараты в соответствии с требояваниями ГОСТ, осуществляют дератацию, дезинфекцию, дезинсекции.
